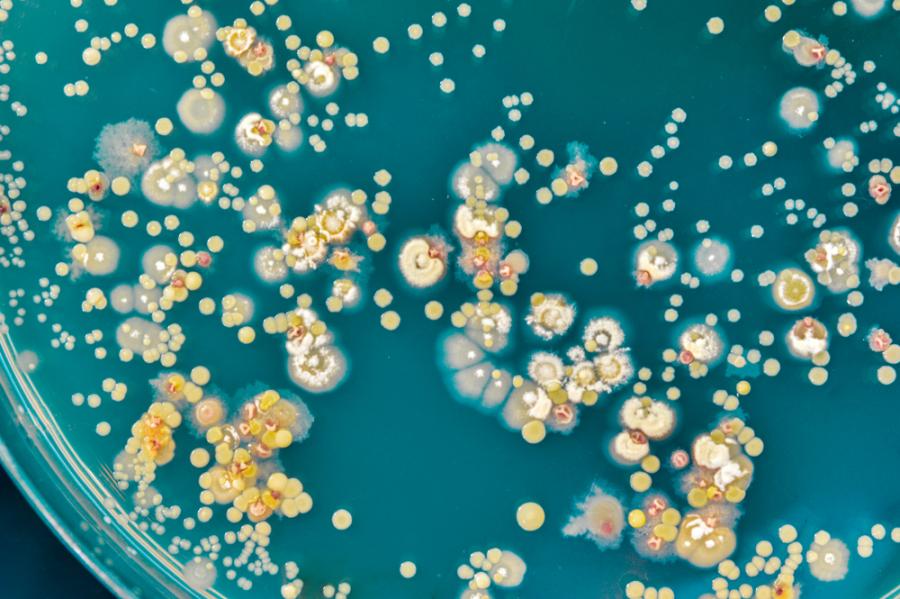

Бактериите се държат "злобно" към онези, които не подкрепят колонията
Бактериалните колонии по-скоро биха извършили „еволюционно самоубийство“, отколкото да се примирят с мързеливите щамове, които живеят на гърба на останалите и не помагат с нищо.
Това откриват изследователи, които създават модел на начина, по който една колония откликва на онези бактерии, които консумират повече, отколкото им се полага.
Бактериите в колонията често работят в тандем, за да оцелеят. Те произвеждат ресурси, които останалите потребяват.
Така например дадена бактерия често отделя ензими, които разграждат източниците на храна в питателни вещества, които са от полза на друга бактерия в съседство.
Понякога обаче съществуват „егоистични“ бактерии, които консумират ресурси, без самите те да допринасят за благото на колонията.
На бактериите, които допринасят за благото на своето общество, никак не им е лесно. „Ето защо ако си егоист, най-добре да взимаш това, което ти се предлага, без да даваш нищо в замяна“, казва водещият автор на изследването Алекс Мофет, изчислителен биолог към Университета Йорк в Торонто. „Очевидно обаче това е лошо за всички. Ето защо обществото трябва да открие как да обезкуражава подобен тип поведение.“
За да определят степента на производство на бихомичните продукти (т.нар. „обществени блага“) в зависимост от гъстата на популацията, бактериалните колонии използват система, наречена кворумно усещане.
Кворумното усещане работи по следния начин – то регулира експресията на кооперативните гени сред дадена популация от бактерии посредством малки молекули, наречени автоиндуктори.
Колкото повече бактерии има, толкова по-голямо количество автоиндуктори се натрупват. Ако концентрацията им се повиши над критичните нива, това задейства промяна в бактериите, които (като група) са надраснали необходимите ресурси.
С помощта на математически модел изследователите откриват, че кворумното усещане наказва готованците, като намалява наличието на споделените ресурси.
В някои случаи обаче наказването на по-мързеливите бактерии намалява шансовете за оцеляване на цялата колония, тъй като и работещите не получават ресурси.
„Не очаквахме да видим това поведение, което можете се нарече и „злобно“, обяснява Андрю Екфорд, изчислителен биолог от Университета Йорк. „То обаче показва, че кворумното усещане е забележително гъвкав инструмент за налагането на справедливост.“
Изследователите описват това поведение като „потенциален пример за демографско стохастично еволюционно самоубийство.“
Математическите модели, разбира се, не са безгрешни. При тях няма нищо сигурно, голяма част от резултатите се базират на предположения. Те обаче представляват особено полезен инструмент, който позволява на учените да научат повече за сложни и динамични системи (в конкретния случай – за бруталните компромиси, които бактериалните колонии правят, за да оцелеят). Това би могло да хвърли повече светлина върху начина, по който бактериалните инфекции се зараждат и предизвикват различни заболявания у хората.
Така например пациентите с цистична фиброза често получават белодробни инфекции, като обикновено устойчивият на лекарства супер микроб Pseudomonas aeruginosa е основният виновник.
P. aeruginosa се настанява в белите дробове и образува малки и плътни биопластове, състоящи се от около 1000 бактериални клетки, които изпълняват ролята на здрав защитен пласт. Това затруднява значително унищожението на бактериите и прочистването на инфекцията с помощта на антибиотици.
Математическият модел на кворумното усещане може да помогне на изследователите да разберат по-добре как бактериите могат да колонизират белите дробове толкова ефективно, а това от своя страна да ги насочи към създаването на нов тип лечения, казва Мофет.
Изследването е публикувано в PLOS Computational Biology.
Източник: Science Alert